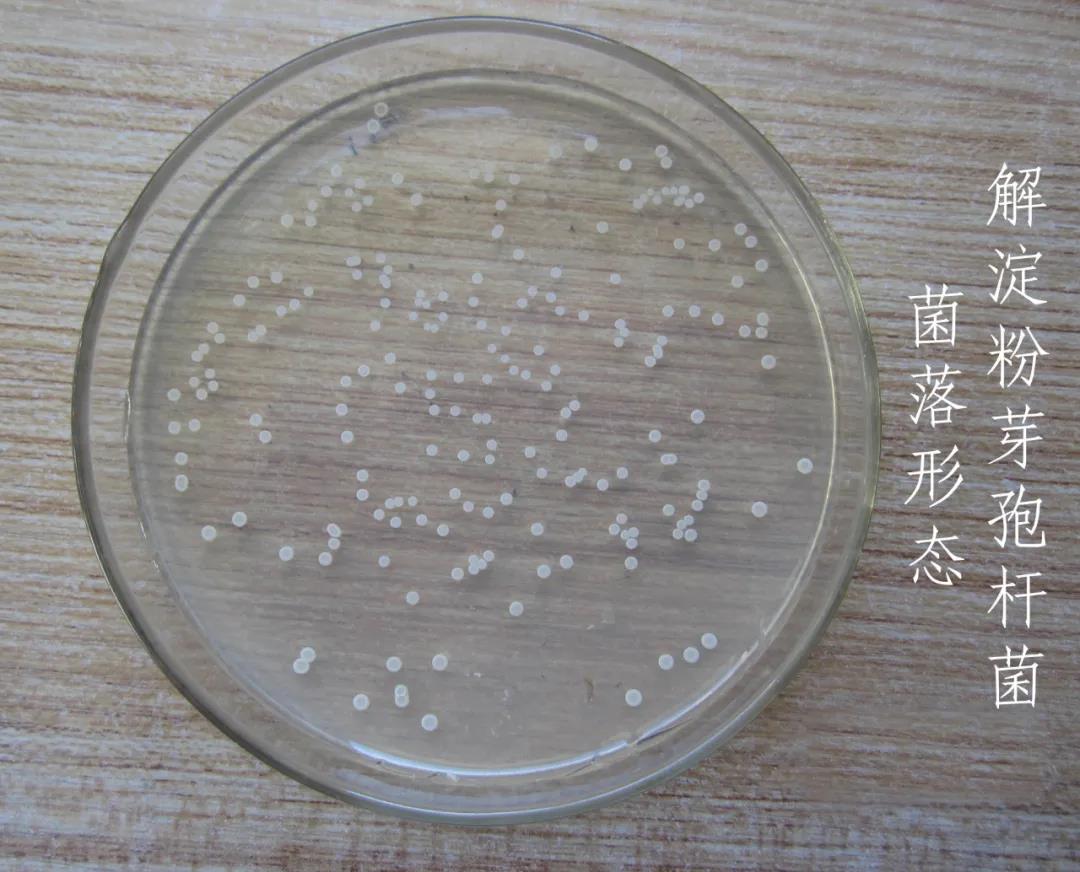

国产女人高潮毛片-伊人情涩网-亚洲欧美日韩在线精品2024-久久精品AⅤ无码中文字字幕-人妻日本无中文字幕无码
地址:山东省.泰安市.泰前
电 话:0538-8505866
传 真:0538-8505966
财富热线:18660886576
解淀粉芽孢杆菌是一种广泛分布于大自然中的革兰氏阳性菌,具有很强应用潜力。解淀粉芽孢杆菌属于芽孢杆菌属,由于它可以产生液化淀粉酶分解淀粉而被命名为解淀粉芽孢杆菌。将解淀粉芽孢杆菌施入土壤或水体中,能够降解自然界中一些有毒物质,净化被污染的土壤和河流湖泊。解淀粉芽孢杆菌又是典型的植物促生菌,能够分泌抗菌蛋白、抗生素、酶或多肽等活性物质,促进植物生长,防治植物真菌病害。由于解淀粉芽孢杆菌能够分泌多种抗菌活性物质,对果蔬表面的病菌有广泛的抗性,能够解决果蔬保鲜和长期储存问题。
解淀粉芽孢杆菌的这些优良特性在环境保护、农业生产方面都有很大应用潜力近年来,解淀粉芽孢杆菌对农业生产的作用逐渐受到重视。现已从土壤、植物根际体表、深海水中以及多种植物体内发现了解淀粉芽孢杆菌。解淀粉芽孢杆菌能通过多种机制与植物互作,能够较好地促进植物生长、控制植物病害、提高作物品质。目前解淀粉芽孢杆菌在农业上的应用主要有以下几点:1) 作为生物肥料促进植株生长,提高植物品质;2)作为水果蔬菜的保鲜剂;3)防治多种植物病害,降低植株感病率。
1、 解淀粉芽孢杆菌作为生物肥料促进植物生长,改善植物品质
化学肥料的大量使用造成蔬菜中硝酸盐含量严重超标,而且该问题在我国越来越普遍。随着人们对食品日益关注,生物肥料成了人们绿色肥。解淀粉芽孢杆菌作为生物肥料的主要成分之一,常被应用于农业生产。刘栓成等]研究发现,用解淀粉芽孢杆菌B9601-Y2浸泡玉米种子一段时间后,可促进种子发芽且幼苗高生长。Zhou等用甘薯淀粉废水发酵生产解淀粉芽孢杆菌作为生物化肥,证明对茶树有促进生长的作用。关晓欢发现解淀粉芽孢杆菌菌液泡不同蔬菜种子,与对照组相比,小白菜种子、木耳菜种子、油菜种子发芽率分别提高44%、136.3%和35%,对小白菜生物量影响不明显;经尿素施肥后再添加柠檬酸废水的发酵菌液可降低蔬菜中硝酸盐和亚硝酸盐含量,且对维生素C含量无影响。所以在当前社会背景下,化学肥料和生物肥料结合使用是可以提高作物产量又降低其硝酸盐含量的理想途径。
2、解淀粉芽孢杆菌在果蔬保鲜上的应用
果蔬的保鲜很大程度决定于对果蔬表面有害生物的控制。在过去的20多年里,生物制剂作为一种防治采后果实腐烂的有效方法而涌现出来。范青等研究解淀粉芽孢杆菌B-912对桃和油桃褐腐病以及对柑橘果实采后青、绿霉病的控制效果后认为,解淀粉芽孢杆菌的抑菌机理为产生抗菌素从而控制病菌的生长。
解淀粉芽孢杆菌已被证实对果蔬病原菌具有防治作用,而且解淀粉芽孢杆菌应用于果蔬采后病害防治有很多优点,但到目前为止,能够进行商业化生产的解淀粉芽孢杆菌菌株却很少。其原因主要有:1)部分解淀粉芽孢杆菌防效不稳定,容易受到环境影响;2)相对于化学农药,解淀粉芽孢杆菌抑菌谱较窄;3)生产成本相对过高;4)解淀粉芽孢杆菌的问题。只有克服这些缺陷,解淀粉芽孢杆菌才能在果蔬保鲜方面成为重要的杀菌保鲜剂。
3、解淀粉芽孢杆菌对植物病害的防控作用
解淀粉芽孢杆菌的生防潜能一直被人们所关注。目前已发现解淀粉芽孢杆菌对多种植物病原菌有控制作用。解淀粉芽孢杆菌的抑菌机制是多方面的,不同的菌株其抑菌机理可能不同,但主要是产生抑菌物质。目前了解的解淀粉芽孢杆菌产生的抑菌物质主要包括甜蛋白、类甜蛋白、抗生素肽类物质、伊枯草菌素、芬枯草菌素、表面活性素、几丁质酶、芽孢素类和细菌素等多种抑菌活性物质。